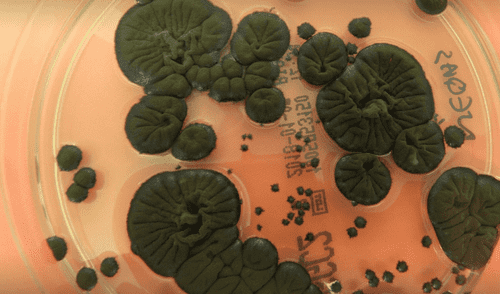
elpopular.pe

¿Un hongo que se alimenta de radiación? ¡Sí! Es difícil de creer que algo que ha crecido en una zona que fue arrasada por la radiación, como Chernóbil, sea la respuesta para la colonización espacial de humanos hacia Marte. En este artículo, te contamos todos los detalles de este impactante descubrimiento.
La comunidad científica lo considera como un "hongo milagroso", ya que ha resistido a las condiciones extremas tras la explosión de la central nuclear de Chernóbil, ocurrido en 1986, evento que cumple 40 años en 2026.
Según National Geographic, estudios científicos han revelado que las condiciones radiactivas fueron esenciales para su conservación; de esta manera, el hongo adaptó sus necesidades y empezó a buscar la radiación como fuente de alimentación.
Cladosporium sphaerospermum: el hongo que come radiación.
Siendo la melamina el principal componente para su supervivencia, esta se trata de un pigmento presente en la piel humana que nos protege de los rayos del Sol. En el caso del hongo, quien lo utilizó para absorber los rayos gamma de la propia radiación, creciendo a través de la radiosíntesis, por lo que se nutre de la radiación.
Durante el 2020, un equipo de la Estación Espacial Internacional optó por realizar un experimento con el fin de evidenciar la utilidad del hongo en la reducción de los niveles de radiación. ¿Qué descubrieron?
Los científicos notaron que los altos niveles de rayos gamma son los principales retos ante la carrera espacial; por ello, el hongo es clave para los viajes espaciales hacia Marte, ya que presenta una capa delgada de 2 milímetros capaz de bloquear una parte significativa de la radiación.
Actualmente, los experimentos con esta especie de hongo continúan luego de 5 años de su prueba inicial. Asimismo, este hallazgo ha generado que otros científicos busquen otros beneficios médicos, en especial para los pacientes con cáncer, quienes usan tratamientos de radioterapia, donde se busca reducir los niveles de radiación.
Periodista especializada en ciencia, tecnología y salud. Bachiller en Periodismo de la Universidad Jaime Bausate y Meza. Redactora en El Popular, interesada en temas relacionados con estudios científicos, eventos astronómicos, hallazgos y más.